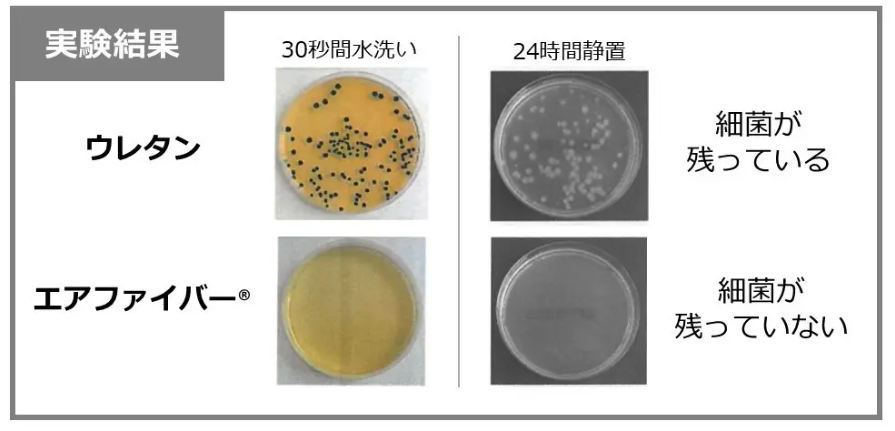

夜しっかり寝たはずなのに、疲れが取れていない…
そんな朝を迎えたことはありませんか?
実は、枕が体に合っていないことが原因で、睡眠の質が下がることも少なくありません。
そこで注目したいのがエアウィーヴピローです。
この枕は、独自素材のエアファイバー®を活用し、体圧を均一に分散させることで快適な寝姿勢をサポートします。実際に「朝のスッキリ感が違う」といった評判も多く、理想の睡眠を目指す方におすすめの枕です。
歴代のオリンピックの選手村でも使用される等、世界基準で信頼されるブランドです。


しかし、どんなに評判の良い枕でも、選び方を間違えると十分な効果が得られないことも。
本記事では、エアウィーヴピローの具体的な特徴や実際の評判を詳しくご紹介しながら、あなたにぴったりのモデルを見つけるためのポイントを解説します!
エアウィーヴピロー 独自テクノロジーが生み出す快眠の秘訣とは
エアウィーヴピローの魅力とは?
優れた通気性を実現する「エアファイバー®」素材
エアウィーヴピローシリーズの最大の特徴は、独自開発されたエアファイバー®素材を使用している点です。この素材は90%が空気でできており、一般的な枕素材と比べて圧倒的な通気性を誇ります。


睡眠中に熱を持ちやすい頭部から熱や湿気を効率よく逃がし、蒸れにくい快適な寝心地を提供します。特に、放熱による深部体温の低下が、深い眠りを促進する助けになるのが魅力ですね。





放熱により深部体温が低下し、深い眠りを促進します
洗える構造で常に清潔
枕を清潔に保ちたいと思うあなたにとって、エアウィーヴピローのもう一つの大きな魅力は、その洗える構造です。カバーはもちろん、中材のエアファイバー®もシャワーで簡単に洗浄できます。これにより、寝汗が気になる方やアレルギーをお持ちの方でも安心して使える衛生的な仕様になっています。


一般的に広く普及しているウレタン素材とポリエチレン樹脂を使用したエアファイバー®素材を用い、洗浄による細菌の除去のしやすさ(洗浄性)と、細菌が付着した状態で24時間静置した場合の菌の残存量(生存性)を比較したところ、エアファイバー®では細菌の残存が少なく、微生物汚染を受けにくいという研究報告も挙がっています。

多様な睡眠スタイルに対応した設計
エアウィーヴピローは、仰向け寝や横向き寝など、さまざまな睡眠スタイルに対応できるよう設計されています。エアファイバー®の適度な反発力が、自然な寝返りをサポートしてくれるのです。
どの体勢でも体圧を分散する設計で、首や頭を安定して支えるため、朝まで快適に眠るためのサポート力が備わっています。特に首には脳に至る大きな血管があるため、圧迫を避けて安定したサポートを提供することが、質の良い睡眠にとって重要です。
エアウィーヴピローのラインナップ
エアウィーヴピローは以下の種類があります。詳しく紹介していきます。


エアウィーヴ ピロー スリム
ちょうどいい高さで、首・肩の負担を軽減。快適な目覚めへ


エアウィーヴ ピロー スリムは、ストレートネックの方や低めの枕が好きな方に向けて、田中みな実さんと共同開発された薄型の枕です。
特徴
スリム&ワイド設計で
寝返りをサポート


横幅 80cmのワイド設計で、一晩に20回以上ある寝返りをスムーズに。低めの高さなので、首や肩に負担をかけにくく、ストレートネックの方にも◎。肩や首への圧力を分散し、寝返りを妨げず、朝の疲労感を軽減 します。
高さ&硬さを自分好みに
カスタマイズできる


枕の中にある2枚のシートコアを抜き差しして、自分の頭に合う高さに調整可能。さらに、「硬め」「柔らかめ」のシートコアの上下を入れ替えることで、好みに合わせたフィット感を実現。ストレートネックや肩こりが気になる方も、理想の寝心地を見つけられます。
田中みな実さんと共同開発
美と健康を考えた理想の枕


「枕難民で低い枕が欲しい」そんな田中みな実さんの希望から生まれたピロー。首や肩への負担を最小限に抑え、快眠をサポート。みな実さんも「理想以上の枕ができた」と語る自信作です。
| 寸法・金額 |
|---|
| 幅約80 × 長さ約33 × 高さ約5~7cm 約 1.0kg ¥17,600(税込) |
口コミ評価
公式サイト:★4.2
Amazon:★4.1
楽天:★4.2
良い口コミ


この枕に変えてから起床後の頭痛が改善されました。高さの低い枕はなかなか売っていないのでありがたいです。


これまでなかなか好みの枕に出会えませんでした。私は低い枕が好きなので、このピロースリムは自分好みの高さです。おまけに長さもあるので、寝返りしてもしっかり枕に頭をおいて寝られます。敷布団もエアウィーヴを使用しているので、毎日の睡眠の質が上がりました!


枕が合わず、就寝中何度も起きてしまったり、首こり肩こりが当たり前でしたが、こちらの商品にしてから眠りも深くなり起床時の首、肩のこりをほとんど感じなくなりました。


寝具で健康で良い睡眠が出来る様になりました。頸椎と腰椎に問題を抱えていたので枕を5種類くらい色々変えてみたのですが最終的にエアウィーヴ ピロー スリムに行きつきました。
マットレスも勿論エアウィーヴです。


絶妙な高さと硬さが最高です。朝起きたときの首の凝りがありません。買ってよかった、、、


ストレートネック、頚椎症の私はどんな枕を使っても合わず、初めてピロースリムを使用するようになってから、朝起きたときに首が痛くなく、寝返りもスムーズになりました。やっと最高の枕に出会えました
※公式サイトより抜粋 画像はイメージです
悪い口コミ


横に幅があるのは良いのですが、もう一段階高さを高くできると良いですね。


硬い
時々目覚めると首が痛くなります。
私には合わなかったようです。柔らかい枕を斜めに重ねて使っています。


私には枕が固かったです。
もう少し高さを高くして、吸収するような素材だったら嬉しかった。
※公式サイトより抜粋 画像はイメージです
上級睡眠健康指導士によるコメント
「起床後の頭痛が解消した」
「起床時の首、肩の凝りが感じなくなった」
「睡眠の質が上がった」
そんな喜びの声が挙がっています。
「高めの枕だと首に負担がかかり、普通の枕は使えない」そんな枕難民を救済する枕です。
特徴でも挙げたように、「硬め」「柔らかめ」2種類のシートコアを入れ替えることで、好みの硬さを選択できます。どちらも高反発で硬さは硬めです。しかし、枕が薄い分、頭がフィットする感覚はあまりありません。
良い口コミが大多数である一方、「硬い」という口コミも一定数あります。柔らかい枕が好みの方は合わないでしょう。硬めの枕が好みの方、今タオルなどで代用している方にとっては寝心地を大きく改善することが期待できます。



みな実ちゃんと開発したのよ!普通の枕で辛いなら一度試してみない?
という枕の声が聞こえてきます。
「どんな枕を使っても合わなかった…」そんな悩みを持つ多くの方が、このエアウィーヴピロースリムで枕難民を卒業しています。普通の枕が合わない方にとって「買ってよかった」と思える枕の一つです。


¥17,600(税込)
\ 快眠の第一歩はこちらから /
エアウィーヴ ピロー S-LINE
理想的な頭の高さで、どんな体勢でもリラックス


エアウィーヴ ピロー S-LINEは、仰向けでも横向けでも、自然な高さを保つように設計されています。
特徴
仰向け・横向きどちらでも
理想の高さをキープ


枕の両サイドを中央より硬めに調整し、寝姿勢が崩れにくい設計。体の軸を自然に保ち、スムーズな寝返りをサポートすることで、首や肩への負担を軽減します。
高さ調整が可能で
自分に合ったフィット感を実現


複数枚のシートコアを抜き差しすることで、枕全体の高さをカスタマイズ可能。体格や寝具の硬さに合わせて調整できるため、ストレートネックの方にもおすすめです。
横向き寝で気道を確保し
呼吸がスムーズに


横向きになったときの頭の高さを適切にキープする設計のため、自然な姿勢で気道が開きやすく、呼吸がスムーズに。いびきの軽減や深い睡眠の確保につながります。
| 寸法・金額 |
|---|
| 幅約40 × 長さ約66 × 高さ約7~11cm 約 1.5kg ¥33,000(税込) |
口コミ評価
公式サイト:★4.3
Amazon:★4.1
楽天:★4.2
良い口コミ


高い枕が苦手な私にはエアウィーヴピローS-LINEはベストな寝心地を与えてくれる最高な枕と言えます!
サイズも他の枕と比べて広いので寝返りを繰り返しても安心です。高さも調節出来るので寝起きの肩凝りも解消されたように感じます。
カバーも中身も洗える清潔感も◎です。


謳い文句どおり寝返りもスムーズ。
首が楽になったせいか眠りの質が良くなりました。


私はあお向けで寝るのが苦手で横向きで寝るのですが、その時少しうつ伏せ気味になっているようで、翌朝首が痛くなっている事が時々ありました。
エアーウィーブの枕に変えてからは、そういう事がありません。横向きにはなるのですが、あの固さがうつ伏せ気味になるのを防いでいるように思われます。
私にとっては少し高額ではありましたが、今は満足しています。


これまで何度も枕を替えました。最初は良いと思っていたのに、次第に合わなくなってきました。
低反発マクラはヘタってくるので私には合いません。
エアウィーヴは高反発なので、買った時の状態が続き、大変満足しています。妻にも勧めました。


ピローS-LINE購入してから寝がいりか楽になりました。朝の目覚めがスッキリです。少々無理して最高ランクのピロー購入してよかったです。


ストレートネックで首、肩凝りが酷く、なかなか合う枕が見付からず枕難民でした。思いきってこの枕を購入し、一番低くしてねてみたらとても快適でした。
朝目覚めた時に、首、肩の痛みがありませんでした。他のまくらは、首が痛くなったり、肩が痛くなったりしましたが、この枕は、快適です。
※公式サイトより抜粋 画像はイメージです
悪い口コミ


横向き寝の人に…ということで購入しましたが、低すぎて横向き寝の私には合いませんでした。
朝起きると肩が痛く、熟睡できませんでした。


思ったより高さが低い、一番高くしてもやはり低い
ベットではなく布団で寝ているので枕が上の方へ逃げて寝ずらい


使い続ければ…とのアドバイスで、今も使っていますが、肩こりがひどくなりました。首に上手くそいません。
※公式サイトより抜粋 画像はイメージです
上級睡眠健康指導士によるコメント
「サイズが大きくて安心して寝返りが打てる」
「寝返りが楽になり朝の目覚めがスッキリ」
「朝目覚めた時の首、肩の痛みがなくなった」
そんな喜びの声が挙がっています。
寝返りは体の圧力を分散させて血流を促し、快適な睡眠をサポートする大切な動作で、平均して一晩で20回ほど行うと言われています。しかし、寝返りのたびに首や肩に余計な負担がかかると、首、肩のこりや痛みの原因になる可能性も大いにあります。
エアウィーヴ ピロー S-LINEは枕の両サイドを中央より硬めにした設計により、寝返り時の動き出しをサポートしてくれます。一番力がかかるところをアシストし、少ない力で寝返りが打てる、そんな枕です。
中央部は柔らかくなっていますが、全体的に硬めです。高さは中のシートコアの抜き差しをすることで調整可能ではあるものの、大きくてふかふかした枕が好みの方にとっては、硬くてコンパクトで「しっくりこない…」と感じてしまうことも…
どちらかというと高反発・やや低めの枕が好みの方におススメです。



寝返りが激しいあなたの味方!しっかりアシストしますよ。
という枕の声が聞こえてきます。
「ストレートネックで朝起きた時の首、肩凝りがひどい…」そんな方にとっては、寝返り時の首肩の負担の小ささと高さをカスタマイズできる点は大きな魅力です。
「少し高額だけど買ってよかった」「人にも薦めたい」買ったらあなたもきっとそう感じる枕です。


¥33,000(税込)
\ 快眠の第一歩はこちらから /
エアウィーヴ ピロー スタンダード
スタンダードなサポート力で、心地よい寝返り


エアウィーヴ ピロー スタンダードは、適度な高さと安定感を兼ね備えた最もベーシックなモデルです。
特徴
シンプルな設計で
初めてのエアウィーヴ枕に最適


エアウィーヴ枕シリーズの基本モデルで、バランスの取れた設計。どのモデルを選べばいいかわからない方でも、これを選べば快適な寝心地を実感できるはずです。多くの方が快眠を実感してきたベストセラーです。
U字型のシートコアが
仰向け寝をサポート


同梱されているU字型のシートコアが頭をしっかりフィットさせ、仰向け寝の姿勢を快適にキープ。首や肩への負担を抑えながら、理想的な寝姿勢をサポートします。
高さを細かく調整できて
首・肩の負担を軽減


S-LINEのようなサイドの硬さ調整はないものの、2枚の調整シートで高さを自由にカスタマイズ可能。また、エアウィーヴ独自の適度な反発力が頭を沈み込みすぎず、しっかり支えてくれるため、肩や首の負担を軽減します。
| 寸法・金額 |
|---|
| 幅約40 × 長さ約56 × 高さ約7~11cm 約 1.0kg ¥22,000(税込) |
口コミ評価
公式サイト:★4.2
Amazon:★4.1
楽天:★4.0
良い口コミ


半信半疑でかいました、枕難民で今まで無かった寝心地で、いびきも少なくなり大変うれしいです。


首が初めて痛くない
運動で首を痛めていろんな枕を試しました。少し高いけど迷いながらもこれを勇気を出して買いました。これからの投資と思って。でも!これが大正解‼️あれから首が痛くて起きることがないです。


今までいろいろな種類や大きさの枕を使ってきましたが、寝ている時の頭のおさまりが万足のいくものがなくてストレスを感じていました。おさまりが悪く夜中に目が覚める時もありました。今回エアウィーヴピローを購入してその日の夜からストレスなく快適に寝ることができました。何故かなあとその理由を考えてみると、頭のおさまりが良く適度な柔らかさというか、硬さというかしっくりときてストレスなく寝ることができます。大きめの大きさも安心することができる一因かと思います。


もともと不眠症気味で枕選びに苦労していました。この枕は適度な固さがあり沈みこまない所が気にいっています。高さ調節できるので、首、肩が楽です。


エアウィーヴピローを使い始めて長年悩み続けてきた肩凝りや寝違えが解消されて快適な生活を過ごせるようになりました。合わない枕をずっと使っている事に気付かず肩凝りに悩まされていたのが嘘のようです。ありがとうございました。


販売店で、高さ調整していただきました。
おかげで、寝付きも良くぐっすりと眠れる毎日です。
もう少し早く購入すればよかったです。
※公式サイトより抜粋 画像はイメージです
悪い口コミ


一般的な素材と違うので好き嫌いは、わかれるかもしれません。横になった時の、寝心地という観点では低めの評価です。


首、肩凝りがひどいのですが、頭が前に出ている私には形状がフィットしませんでした。ただ、高反発素材はいいと思います。


枕ジプシーになって長い年月が経ちました。
中のシートを二枚とも取り除いてはみたもののやはり合いません。軽いので睡眠中に枕が飛んで逃げてしまうこともあります。肩首に張りが出て、酷い時は首が回りません。
※公式サイトより抜粋 画像はイメージです
上級睡眠健康指導士によるコメント
「寝つきが良くなった」
「夜のストレスがなくなった」
「長年悩んでいた肩凝りや寝違えがなくなった」
そんな喜びの声が挙がっています。
仰向けで寝る場合、中央のU字型のシートコアに頭がフィットし、理想的な寝姿勢をつくるサポートをします。


理想的な枕の高さは、仰向けの状態で頭を乗せたときに、額より顎の先がやや(5度程度)下がっている状態と言われています。エアウィーヴ ピロー スタンダードは、頭部をしっかり支える適度な反発力で理想的な高さを保ちます。
引用:エアウィーヴ公式
S-LINEが両サイドのみ硬めなのに対して、エアウィーヴ ピロー スタンダードは全体的に硬め。高反発・硬めの枕でしっかりとした寝心地が高評価です。S-LINE同様に、高さは中のシートコア2枚の抜き差しをすることで7~11cmの幅で2cm刻みで調整可能です。極端に低い枕が好みの方、横寝が多く高めの柔らかい枕が好みの方以外にはおすすめできます。



あなたの理想の寝姿勢作りとスムーズな寝返りのために全力サポートします!
という枕の声が聞こえてきます。
人生の1/3を過ごす寝具。理想的な寝姿勢はとても大切です。「長年悩んでいた肩凝りや寝違え」が解消できたという声も納得です。あなたの同じ悩みにも、強力な武器となるかもしれません。


¥22,000(税込)
\ 快眠の第一歩はこちらから /
エアウィーヴ ピロー ソフト
やさしく包み込む、ソフトな感触の枕


柔らかい感触が好きなあなたには、エアウィーヴ ピロー ソフトが最適です。
特徴
柔らかい寝心地で
首・肩の負担を軽減


エアウィーヴ ピロー ソフトは、シリーズで最もやわらかい寝心地を追求したモデル。頭部が心地よく沈み込み、包み込まれるような感触でリラックスした眠りをサポートします。硬めの枕が苦手な方や、首・肩の緊張をほぐしたい方におすすめです。
仰向け寝が多い人に
ぴったりの設計


頭部をやさしく支えるリング状のコアが、自然な姿勢での仰向け寝をサポート。適度な沈み込みとフィット感で、首や肩への負担を和らげ、長時間の睡眠でも快適な寝姿勢を維持できます。
高さ調整が可能で
自分に合った快適なポジションに


付属のシートコアを抜き差しすることで、高さを細かく調整可能。体型や寝具の硬さに合わせてカスタマイズできるため、理想の寝姿勢をサポートし、快適な眠りを実現します。
| 寸法・金額 |
|---|
| 幅約40 × 長さ約56 × 高さ約7~11cm 約 1.0kg ¥22,000(税込) |
口コミ評価
公式サイト:★4.0
Amazon:★4.1
楽天:★4.2
良い口コミ


ずっと枕難民をしていて、一か月試してみられるしと思い、オンラインショップで購入しました。
頭の置き場所があるせいか首が痛くなることもなくなり、眠りに落ちるのも早くなったように思います。仰向けでも横向きでも無理なく楽な姿勢がとれます。中がファイバーなので寒い?と思いましたが関係ないかなと感じます。朝に首が痛くていてて…と起きていたのがなくなりスッキリ起きられて快適です。


10年以上色々な枕を試して初めて納得がいく枕に出会えました
これから長く使って行きたいので中まで洗えるのがとてもいいです


理想の枕に出会えました。
今までも枕にはお金をかけてきましたが、高さや硬さが合わなかったり、熱がこもったりして、これといったものには出会えませんでしたが、こちらの枕はピッタリです。


腰痛があり、いろいろな寝具やマットレスを試して来ました。エアウィーを使い初めて本当に楽になりました加えて、肩こりもとても改善しました。もっと早く使っていれば良かったと思います。改めて眠りの大事なこと、それは自分を大事にすることたと気がつきました。いまは眠る時間が大好きです。


やわらかい低めの枕が好みで、寝るクセは仰向けです。ソフトタイプを購入しました。
①通気性がよく熱がこもらない。
②高さ調整ができるので好みの感じにセットできた
③寝姿勢が自然に保たれ身体のどこにもストレスを感じない。
➃頭が枕に触れた感触が軽い。
⑤快適な睡眠がとれている。
という訳で今のところ満足しています。


今まで沢山の枕を購入してきました。なかなか合う枕がなかったので期待はあまりしておりませんでしたが、思った以上に良く寝れます。
とてもおすすめできる商品です。良い商品に出会えてよかったです。
※公式サイトより抜粋 画像はイメージです
悪い口コミ


店舗で試し 、今までで一番ちょうどいい高さだったので購入。購入直後かもしれないが、膨らみすぎてシートコア抜いても高すぎて首が締まって寝れない。今は身体で押し潰して半分の高さになるまで矯正中です。なかなかぺちゃんこにならない。


かなり固めで、設置面の圧迫を感じるぐらい。
元々柔らかめ枕が好みのわたしには不向きでした。


高さが少し低かった点と初めは良かったんですが時間が経つと頭皮が痺れる感じがして目が覚めてしまう。
※公式サイトより抜粋 画像はイメージです
上級睡眠健康指導士によるコメント
「肩こりがとても解消した」
「身体のどこにもストレスを感じない」
「理想の枕に出会えた」
そんな喜びの声が挙がっています。
エアウィーヴ ピロー ソフトはエアウィーヴの枕の中で最も柔らかい寝心地が特徴です。エアウィーヴの枕は全体的に高反発でかなり硬めの寝心地ですが、このエアウィーヴ ピロー ソフトはエアウィーヴの枕の中で最も柔らかい寝心地が特徴です。
エアウィーヴの枕は全体的に高反発でかなり硬めの寝心地ですが、ソフトはバランス良く、「エアウィーヴ、初めてだけど硬すぎないか不安…」という方はまずこの枕がおすすめです。
良い口コミが大多数である一方、「硬い」という口コミも一定数あります。エアウィーブの枕の中では柔らかめなものの、沈むような柔らかさではないため、柔らかく包み込むような柔らかさが好みの方には合わない場合も…。
しかし、



エアウィーヴの枕の中で、私が一番柔らかく、違和感が少ない自信がありますよ。
という枕の声が聞こえてきます。
しかし、エアウィーヴ ピロー ソフトを使って「理想の枕に出会えて、枕難民を卒業」という声も多く、なかなかしっくりくる枕が無くて悩んでいる人は試す価値ありと思います。
「高さ、硬さ、熱のこもり」枕選びで悩むポイントをバランスよく解消して、眠る時間が大好きになる。そんな期待が持てる枕です。


¥22,000(税込)
\ 快眠の第一歩はこちらから /



さすがエアウィーヴ!沢山の枕難民を救済しているのね
でも結局どれが良いのかしら…
他にも以下のポイントも気になるわ
エアウィーヴピローのQ&A
エアウィーヴピローの選び方
枕選びは簡単ではなく、「結局どれが自分に合っているか?」と悩んでいる方も多いのではないでしょうか。



悩むポイントを加味して、選び方を図示してみました


枕を選ぶポイントの、硬さ、高さ、寝姿勢の3つを元に最適な枕を選べます。もし迷った際には参考にしてみてくださいね。
枕の耐久性は?
は2年です。へたりや凹み、生地の経年劣化や、ダニやカビ等の衛生面での問題等を考慮して、良い状態で使用できる期間という前提です。
どうすれば安く買える?
エアウィーヴ ピローを安く購入する方法として、以下のパターンがあります。
🎁公式サイトでのキャンペーン
例年、期間限定で行っていますが、商品の割引でなく、設置・配送が無料になるキャンペーンが主です。
🎁楽天市場のセールを活用
楽天スーパーセールやお買い物マラソンでは 20〜30%OFF になることも。ポイント還元もあるので、公式よりお得に購入可能です。
📌新店舗オープン時のキャンペーンを狙う
エアウィーヴが新店舗を出す際、割引やセット販売のキャンペーンを実施することがあるので要チェックです。
📌ふるさと納税の返礼品でお得にゲット
愛知県幸田町などの自治体で、エアウィーヴの枕やマットレスを返礼品として提供。実質負担額を抑えて入手可能です。
返品・交換はできる?
公式サイトで購入すると、30日間返品可能です。ただし、汚れ・破損がないこと、初回注文(1点)のみといった条件があります。
枕のお手入れの仕方は?
エアファイバー®は水洗いできるのが大きな魅力。でも正しい方法でお手入れしないと、思わぬダメージが…。だからこそ、ここでのコツが重要です。特に、40〜45度のシャワーで洗えばふっくら感も取り戻せるため、身体に合った形状で長く衛生的に使いたい場合にオススメです。
👌水洗いのみ使用
洗剤や漂白剤は不要!ぬるま湯とシャワーで優しく洗い流してください。
❌ 絞るのはNG、優しく水切り
洗った後は中材を軽く押して水を切ります。ギュッと絞ると形が崩れる原因になるので要注意。
👍乾燥は日陰で自然に
直射日光や高温乾燥機は厳禁。日陰でじっくり乾燥させてください。
尚、枕カバーに関しては家庭用洗濯機で洗濯可能です。
まとめ
エアウィーヴピローは、独自素材「エアファイバー®」を活用し、体圧分散や快適な寝姿勢をサポートすることで、多くの方の悩みに応えてきました。
それでも、「本当に自分に合うのか?」と迷う気持ちがあるのも自然なことです。
でも安心してください。エアウィーヴでは、30日間のお試し制度や、店舗での試用ができる仕組みを用意しています。実際に試してみて、自分の体にフィットするかじっくり確かめられるのは、大きな安心感ですよね。
枕が変わるだけで、朝の目覚めがスッキリし、日中の活力や幸福感が高まるとしたら、その効果は計り知れません。まずは一歩踏み出し、あなたにぴったりの枕を見つけてみてはいかがでしょうか?
ぜひ次の行動に進んで、理想の睡眠環境を手に入れてください!
当サイト一押し!田中みな実さんと共同開発の枕


¥17,600(税込)
\ 快眠の第一歩はこちらから /








コメント